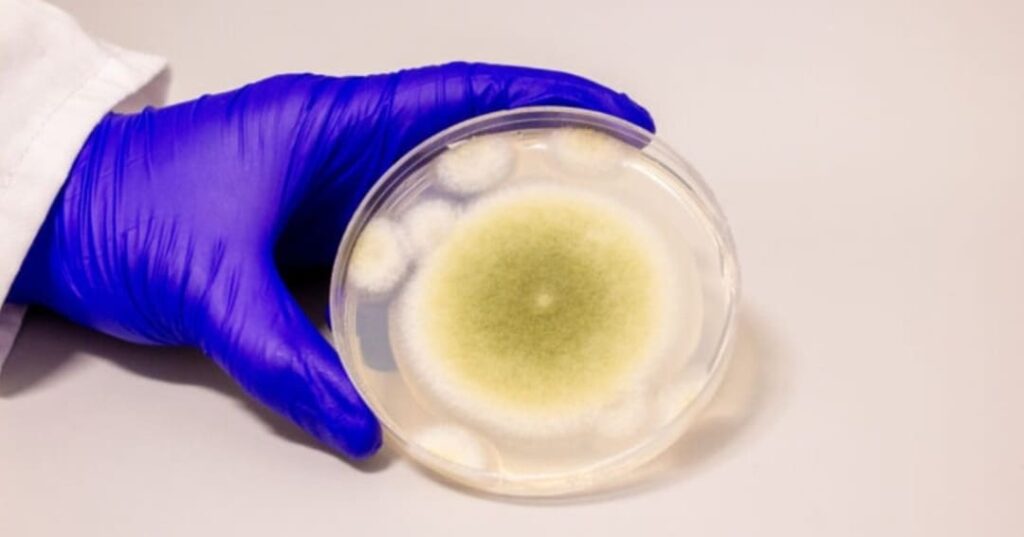
Aspergillus flavus

Mediante la modificación de moléculas aisladas extraídas del hongo tóxico Aspergillus flavus, investigadores de Penn desarrollan un compuesto anticancerígeno con potencial médico.
Científicos de la Universidad de Pennsylvania han transformado un hongo peligroso en un poderoso agente contra el cáncer. Después de aislar una nueva categoría de moléculas del Aspergillus flavus, un hongo dañino para los cultivos y asociado a muertes en excavaciones arqueológicas, los investigadores alteraron estas sustancias químicas y las evaluaron en células leucémicas.
El compuesto resultante mostró un gran potencial como tratamiento anticancerígeno, comparable a medicamentos aprobados por la FDA, y abre camino para la exploración de nuevos fármacos derivados de hongos.
Propiedad anticancerígena
“Los hongos nos dieron la penicilina”, afirma Sherry Gao, autora principal de un nuevo artículo sobre los hallazgos. Estos hallazgos evidencian que todavía hay muchos medicamentos derivados de productos naturales por descubrir.
El hongo Aspergillus flavus, conocido por sus esporas amarillas, ha sido responsable de numerosas muertes entre excavadores de tumbas debido a sus toxinas, que pueden causar infecciones pulmonares, en especial en personas con sistemas inmunológicos debilitados.

Ahora este mismo hongo se ha convertido en una fuente inesperada de una nueva y prometedora terapia contra el cáncer. Esta terapia se basa en una clase de péptidos sintetizados por el ribosoma y luego modificados, conocidos como RiPP, término que alude al ribosoma, la estructura celular encargada de producir proteínas. Aunque se han identificado miles de RiPP en bacterias, solo se han descubierto unos pocos en hongos.
“La síntesis de estos compuestos es compleja. Pero eso también es lo que les confiere esta notable bioactividad”.
afirma Qiuyue Nie, primera autora del artículo.

Buscando más RiPP fúngicas, se examinaron inicialmente una docena de cepas de Aspergillus, las cuales, según estudios previos, podrían contener una mayor concentración de estas moléculas. Comparando los compuestos químicos producidos por estas cepas con las características básicas conocidas de las RiPP, identificaron a A. flavus como candidato prometedor para nuevas investigaciones.
El análisis genético reveló que una proteína específica de A. flavus era la responsable de producir RiPP fúngicas. Al inactivar los genes encargados de sintetizar dicha proteína, los indicadores químicos asociados a la presencia de RiPP desaparecieron.

Este innovador método, que combina datos metabólicos y genéticos, no solo permitió identificar el origen de las RiPP fúngicas en A. flavus, sino que también abre la posibilidad de descubrir más RiPP fúngicas en el futuro.
Después de aislar cuatro RiPP diferentes, los científicos observaron que estas moléculas, hasta entonces desconocidas, compartían una estructura única de anillos entrelazados.

Las moléculas fueron llamadas asperigimicinas, en honor al hongo que las originó. Incluso sin nuevas modificaciones, al exponerse a células cancerosas humanas, las asperigimicinas mostraron un potencial terapéutico notable. Dos de las cuatro variantes demostraron efectos potentes contra células leucémicas.
FUENTE / IMÁGENES: Nature.
IMÁGENES ADICIONALES: Pexels.